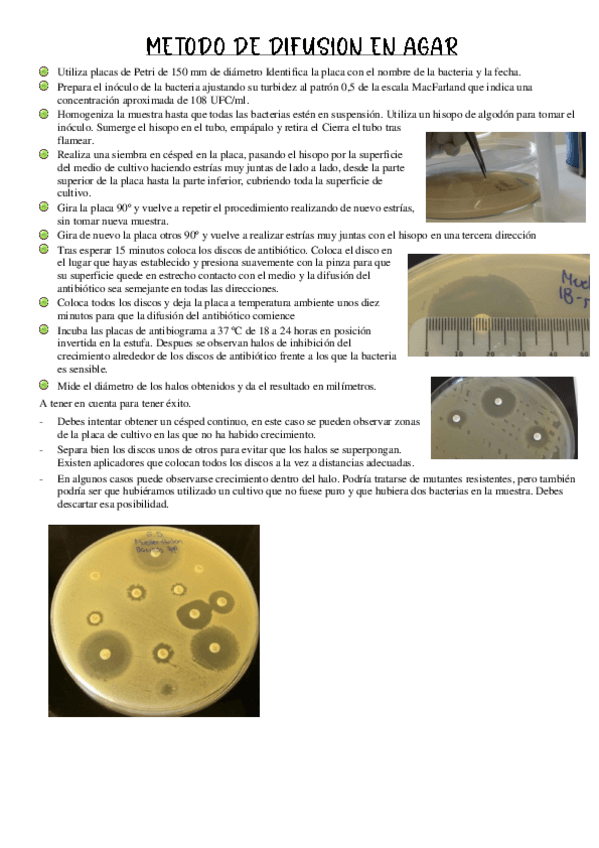

@Estefy097
28 Publicaciones
160 Interacciones
3 Seguidores
7 Siguiendo
Lista de publicaciones de Estefy097
ingles laboratorio clinico ç
He publicado nuevos apuntes de Gestión de Muestras Biológicas: Tema-3.-La-fase-preanalitica.pdf
He publicado nuevos apuntes de Gestión de Muestras Biológicas: Tema-2.-La-documentacion-del-laboratorio.pdf
He publicado nuevos apuntes de Gestión de Muestras Biológicas: Tema-1.-Los-Sistemas-Sanitarios.pdf
He publicado nuevos apuntes de Biología Molecular y Citogenética: Tema-5.-Tecnicas-basicas-de-aalisis-molecular..pdf
He publicado nuevos apuntes de Biología Molecular y Citogenética: Tema-4.-Tecnicas-de-hibridacion-de-acidos-nucleicos..pdf
He publicado nuevos apuntes de Técnicas de análisis hematológico: Tema-3-Aplicacion-de-tecnicas-de-analisis-hematologico-al-estudio-de-serie-roja.pdf
He publicado nuevos apuntes de Técnicas de análisis hematológico: Tema-2-Manejo-de-equipos-hematopoyeticos.pdf
He publicado nuevos apuntes de Técnicas de inmunodiagnóstico: Tema-1-Tecnicas-de-antigeno-anticuerpo.pdf
He publicado nuevos apuntes de Técnicas de inmunodiagnóstico: Reacciones-de-Identidad.pdf
He publicado nuevos apuntes de Técnicas de inmunodiagnóstico: Tecnicas-avidina-biotina.pdf
He publicado nuevos apuntes de Técnicas de inmunodiagnóstico: coombs-directo.pdf
He publicado nuevos apuntes de Técnicas de inmunodiagnóstico: coombs-indirecta.pdf
He publicado nuevos apuntes de Microbiología Clínica: Tema-3-Protocolo-de-identificacion-bacteriana.pdf
He publicado nuevos apuntes de Microbiología Clínica: Galerias-api-y-antobiograma.pdf
He publicado nuevos apuntes de Microbiología Clínica: Medios-de-rutina.pdf
He publicado nuevos apuntes de Microbiología Clínica: Tecnicas-de-cultivo-aislamiento-y-recuento-bacteriano.pdf
He publicado nuevos apuntes de Microbiología Clínica: Tema-1.-El-laboratorio-de-microbiologia-clinica.pdf